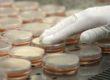

Durham Fire-Rescue Hazardous Supplies Staff is main the way in which in utilizing new and present gear to decontaminate surfaces that will have been uncovered to COVID-19.
Firefighters swimsuit up in Tyvek hazmat gear to spray all surfaces with chlorine dioxide.”Chlorine dioxide has been proven in a number of research and by a number of federal companies to kill the COVID-19 virus,” stated Ryan Campbell with the Durham Fireplace Division.
To scrub a complete firehouse, he says that it may be executed by mixing packets of chlorine dioxide with water in a cup that units off a gasoline aroma. The cleansing and air flow course of can take as much as 5 hours.
Durham firefighters are carrying extra donated masks made by people and native companies.
“We’re making an attempt to get 1,200. We’re about midway there,” stated Durham Fireplace Chief Robert Zoldos. “And that can give all our individuals, about 400 on-duty personnel three masks a chunk.”
Quickly Durham Fireplace can be making its personal N95 masks with the acquisition of 3D mask-making machines.
“We will do five-a-day, seven-days-a-week, stated Captain Don Gross. “Principally inside 4 hours, you may have a masks.”
Durham Fireplace Division additionally bought two $300 ovens and put in them behind a truck to kill viruses on Private Protecting Gear. Campbell says crews will put PPE within the oven and switch up the warmth to 167 degrees– within the occasion there is a gear scarcity.
Durham Hazmat crew says it is one of many few companies within the state utilizing these methods.
On Thursday, they confirmed them off to Raleigh and Cary hearth departments, and different emergency administration groups and transportation personnel in Durham.
The cash for the gear is popping out of their finances for working bills. The Deputy Chief for the Durham Fireplace Division stated it prices $1,000 for the ovens and supplies to place it within the SUV, printers run about $650 and the printing filaments price a pair hundred {dollars}.The home made sprayers price the division about $85 in elements.